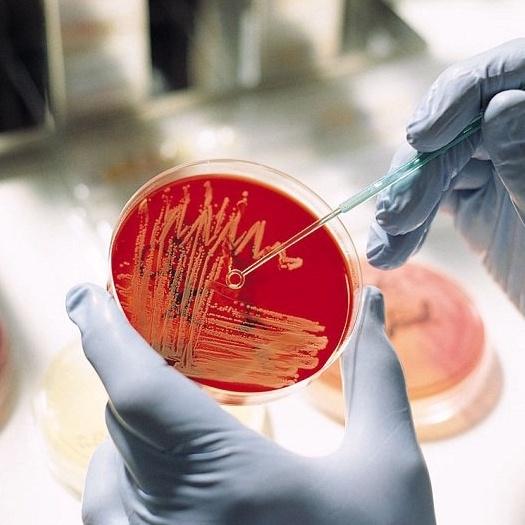

ĐĨA PETRI THUỶ TINH 90MM HỘP LỒNG PETRI MỘT NGĂN TRUNG QUỐC
Thương hiệu: OEM | Xem thêm các sản phẩm Dụng cụ làm đẹp của OEMMô tả ngắn
Sản phẩm được dùng cho các ứng dụng sinh học, y tế, quan sát dưới kính hiển vi, chất liệu thủy tinh trong suốt, nắp phẳng đồng nhất Có thể được khử trùng như hấp trong nồi hoặc sấy khô trong lò ...- Giao hàng toàn quốc
- Được kiểm tra hàng
- Thanh toán khi nhận hàng
- Chất lượng, Uy tín
- 7 ngày đổi trả dễ dàng
- Hỗ trợ xuất hóa đơn đỏ
Giới thiệu ĐĨA PETRI THUỶ TINH 90MM HỘP LỒNG PETRI MỘT NGĂN TRUNG QUỐC
Sản phẩm được dùng cho các ứng dụng sinh học, y tế, quan sát dưới kính hiển vi, chất liệu thủy tinh trong suốt, nắp phẳng đồng nhất
Có thể được khử trùng như hấp trong nồi hoặc sấy khô trong lò ở nhiệt độ 160 °C trong khoảng một giờ
- Đường kính 90mm, có thể hấp tiệt trùng
- 1 cái gồm có 2 nắp
- Dễ xếp chồng
- Thủy tinh có độ dày tốt nên chịu được nhiệt độ hấp tiệt trùng, chắc chắn
- Xuất xứ: Trung Quốc
Giá sản phẩm trên Tiki đã bao gồm thuế theo luật hiện hành. Bên cạnh đó, tuỳ vào loại sản phẩm, hình thức và địa chỉ giao hàng mà có thể phát sinh thêm chi phí khác như phí vận chuyển, phụ phí hàng cồng kềnh, thuế nhập khẩu (đối với đơn hàng giao từ nước ngoài có giá trị trên 1 triệu đồng).....
Hình ảnh sản phẩm



Giá ARDR
Thông tin chi tiết
| Thương hiệu | OEM |
|---|---|
| Xuất xứ thương hiệu | Việt Nam |
| Xuất xứ | Việt Nam |
| SKU | 9020738677012 |
Từ khóa
miếng dán ngải cứu đai chống gù lưng dầu nóng hàn quốc tam nuoc halio dán trắng răng bàn chải điện bàn chải điện ps bàn chải ps sơn móng tay nhíp nhặt lông yến chà gót chân máy chà gót chân bộ lấy ráy tai chuyên nghiệp kéo tỉa lông mũi thảm tập yoga miếng dán thải độc chân áo choàng cắt tóc bộ lấy ráy tai lọ chiết nước hoa chiết nước hoa chai chiết nước hoa lọ chiết mỹ phẩm gel bôi trơn máy xông mũi họng trị covid máy massage mặt nâng mũi kẹp nâng mũi cao máy xông mặt cây nặn mụn